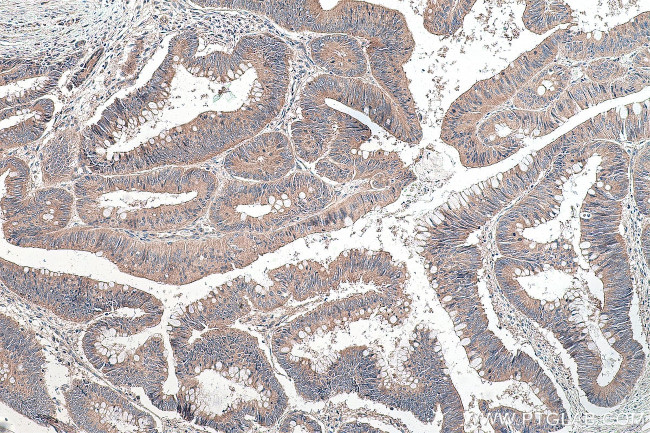
NSUN6 Antibody in Immunohistochemistry (Paraffin) (IHC (P))

Search
Proteintech
NSUN6 Polyclonal Antibody
{{$productOrderCtrl.translations['antibody.pdp.commerceCard.promotion.promotions']}}
{{$productOrderCtrl.translations['antibody.pdp.commerceCard.promotion.viewpromo']}}
{{$productOrderCtrl.translations['antibody.pdp.commerceCard.promotion.promocode']}}: {{promo.promoCode}} {{promo.promoTitle}} {{promo.promoDescription}}. {{$productOrderCtrl.translations['antibody.pdp.commerceCard.promotion.learnmore']}}
产品信息
17240-1-AP
种属反应
宿主/亚型
分类
类型
抗原
偶联物
形式
浓度
规格
纯化类型
保存液
内含物
保存条件
运输条件
产品详细信息
Immunogen sequence: AQCGNAVLR GAHVYAPGIV SASQFMKAGD VISVYSDIKG KCKKGAKEFD GTKVFLGNGI SELSRKEIFS GLPELKGMGI RMTEPVYLSP SFDSVLPRYL FLQNLPSALV SHVLNPQPGE KILDLCAAPG GKTTHIAALM HDQGEVIALD KIFNKVEKIK QNALLLGLNS IRAFCFDGTK AVKLDMVEDT EGEPPFLPES FDRILLDAPC SGMGQRPNMA CTWSVKEVAS YQPLQRKLFT AAVQLLKPEG VLVYSTCTIT LAENEEQVAW ALTKFPCLQL QPQEPQIGGE GMRGAGLSCE QLKQLQRFDP SAVPLPDTDM DSLREARRED MLRLANKDSI GFFIAKFVKC KST (118-469 aa encoded by BC035778)
靶标信息
NSun6 is an RNA methyltransferase that catalyzes the methylation at position cytosine C72 in some tRNAs. NSUN6 has been reported to localize to the cytoplasm and largely colocalize with Golgi apparatus and pericentriolar matrix, indicating that NSUN6 modifies tRNAs in a late step in their biogenesis. NSun6 may also play a major role in bone metastasis and could be a valuable therapeutic target for bone metastasis.
仅用于科研。不用于诊断过程。未经明确授权不得转售。
生物信息学
蛋白别名: ARL5B antisense RNA 1; NOL1/NOP2/Sun and PUA domain-containing protein 1; NOL1/NOP2/Sun domain family 6; NOL1/NOP2/Sun domain family member 6; NOL1/NOP2/Sun domain family, member 6; NOP2/Sun domain family, member 6; NOP2/Sun RNA methyltransferase family member 6; nucleolar protein (NOL1/NOP2/sun) and PUA domains 1; putative methyltransferase NSUN6; tRNA (cytosine(72)-C(5))-methyltransferase NSUN6; unnamed protein product
基因别名: 4933403D21Rik; 4933414E04Rik; ARL5B-AS1; MRT82; NOPD1; NSUN6
UniProt ID: (Human) Q8TEA1, (Mouse) Q7TS68
Entrez Gene ID: (Human) 221078, (Rat) 307148, (Mouse) 74455